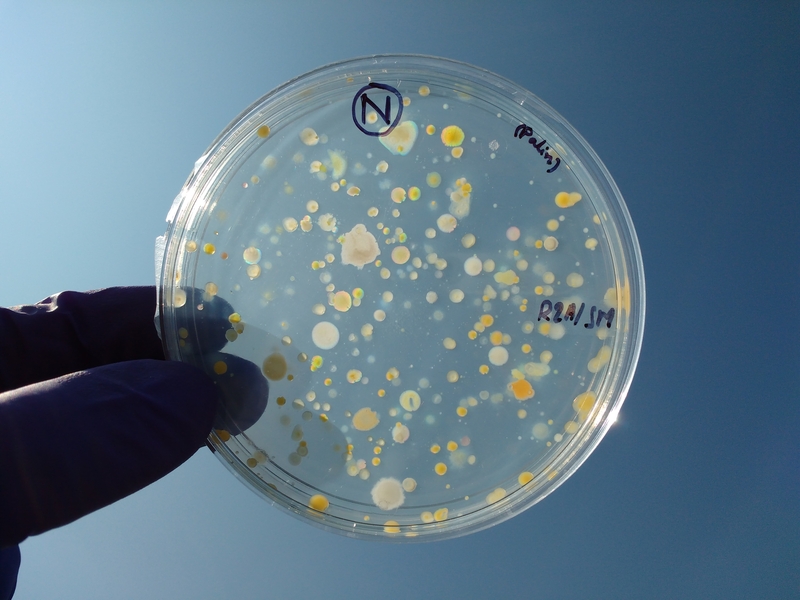

Bestand:Agar Plate Under Sun.jpg
Uit Wiki Raamsdonk
Agar_Plate_Under_Sun.jpg (800 × 600 pixels, bestandsgrootte: 293 kB, MIME-type: image/jpeg)
Beschrijving
Importing file
Bestandsgeschiedenis
Klik op een datum/tijd om het bestand te zien zoals het destijds was.
| Datum/tijd | Miniatuur | Afmetingen | Gebruiker | Opmerking | |
|---|---|---|---|---|---|
| huidige versie | 12 nov 2025 06:17 |  | 800 × 600 (293 kB) | Maintenance script (overleg | bijdragen) | == Beschrijving == Importing file |
U kunt dit bestand niet overschrijven.
Bestandsgebruik
Dit bestand wordt op de volgende pagina gebruikt: